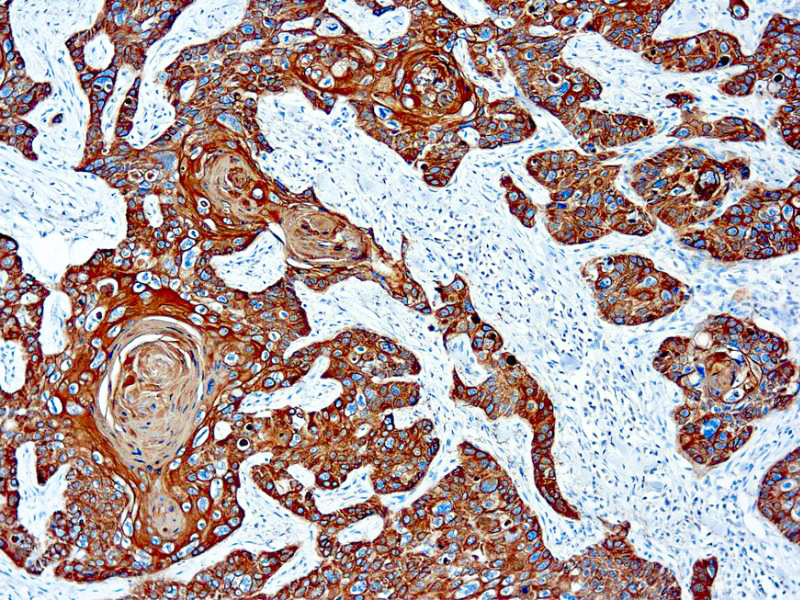

This antibody recognizes basic (Type II or HMW) cytokeratins, which includes 67kDa (CK1); 64kDa (CK3); 59kDa (CK4); 58kDa (CK5); 56kDa (CK6); 52kDa (CK8). This antibody recognizes 65-67, 64, 59, 58, 56, and 52kDa keratins of basic subfamily. Many studies have shown the usefulness of keratins as markers in cancer research and tumor diagnosis.
Cytokeratin AE3, Basic
SKU: 8385
Categories: Primary Antibodies, IVD - For U.S. Market, IVD - Outside U.S. Market
Tags: Concentrated, C
Description
Additional information
| Clone | AE3 |
|---|---|
| Isotype | IgG1, kappa |
| Immunogen | BALB/C mice were immunized with human epidermal keratin. |
| Species | Mouse |
| Cellular Localization | Cytoplasm |
| Positive Control Tissue | Squamous Lung Carcinoma |
| Pretreatment | EDTA Buffer pH 8.0 |
| Incubation & Temperature | 30 min @ RT |
| Intended Use | IVD |
| Detection System | PolyVue Plus – Two Step Detection System Montage PolyVue Plus Auto Detection System for Montage 360 System |
| Description/Type | Mouse Monoclonal Antibody |
| Format | This product is supplied as a Protein G purified antibody from CL1000 in vitro production and contains sodium azide as a preservative. |
DATASHEETS & SDS
DATASHEETS & SDS
| Download Datasheet |
| Download SDS Sheet – OSHA |
REFERENCES
REFERENCES
- Woodock-Mitchell J et. al. Journal of Cell Biology 1982;95:580-8.
- Tseng SCG et. al. Cell 1982; 30361.
Reviews (0)
Only logged in customers who have purchased this product may leave a review.

Reviews
There are no reviews yet.